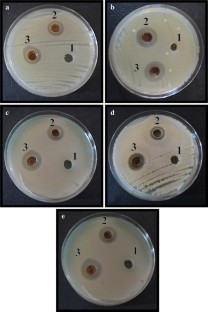

Abstract
The aim of this study was to biosynthesis silver nanoparticles from the fungus Nigrospora sphaerica isolated from soil samples and to examine their activity against five human pathogenic strains of bacteria viz. Escherichia coli, Proteus mirabilis, Pseudomonas aeruginosa, Salmonella typhi and Staphylococcus aureus using disc diffusion method. The synergistic effect of silver nanoparticles in combination with commonly used antibiotic Gentamycin against the selected bacteria was also examined. The synthesized silver nanoparticles from free-cell filtrate were characterized by using UV–Vis spectrophotometer analysis, Fourier transform infrared spectroscopy (FTIR) and scanning electron microscope (SEM). UV–Vis spectrophotometer analysis showed a peak at 420 nm indicating the synthesis of silver nanoparticles, FTIR analysis verified the detection of protein capping of silver nanoparticles while SEM micrographs revealed that the silver nanoparticles are dispersed and aggregated and mostly having spherical shape within the size range between 20 and 70 nm. The synthesized silver nanoparticles exhibited a varied growth inhibition activity (15–26 mm diam inhibition zones) against the tested pathogenic bacteria. A remarkable increase of bacterial growth inhibition (26–34 mm diam) was detected when a combination of silver nanoparticles and Gentamycin was used. A significant increase in fold area of antibacterial activity was observed when AgNPs in combination with Gentamycin was applied. The synthesized silver nanoparticles produced by the fungus N. sphaerica is a promising to be used as safe drug in medical therapy due to their broad spectrum against pathogenic bacteria.

Similar content being viewed by others
References
Ahmad A, Mukherjee P, Senapati S, Mandal D, Khan MI, Kumar R, Sastry M (2003) Extracellular biosynthesis of silver nanoparticles using the fungus Fusarium oxysporum. Colloid Surf 28:313–318
Aymonier C, Schlotterbeck U, Antonietti L, Zacharias P, Thomann R, Tiller JC, Mecking S (2002) Hybrids of silver nanoparticles with amphiphilic hyperbranched macromolecules exhibiting antimicrobial properties. Chem Commun 24:3018–3029
Birla S, Tiwari VV, Gade AK, Ingle AP, Yadav AP, Rai MK (2009) Fabrication of silver nanoparticles by Phoma glomerata and its combined effect against Escherichia coli, Pseudomonas aeruginosa and Staphylococcus aureus. Lett Appl Microbiol 48:173–179
Chitra K, Annadurai G (2013) Bioengineered silver nanobowls using Trichoderma viride and its antibacterial activity against Gram-positive and Gram-negative bacteria. J Nanostruct Chem 39:3–9
Domsch KH, Gams W, Anderson TH (1980) Compendium of soil fungi. Academic Press, London
Ellis MB (1971) Dematiaceous hyphomycetes. Commonwealth Mycol Inst Kew Surrey, England
Ellis MB (1976) More dematiaceous hyphomycetes. Commonwealth Mycol Inst, Kew Surrey
Fayaz AM, Balaji K, Girilal M, Yadav R, Kalaichelvan PT, Venketesan R (2010) Biogenic synthesis of silver nanoparticles and their synergistic effect with antibiotics: a study against Gram positive and Gram-negative bacteria. Nanomedicine 6:103–109
Feng QL, Wu J, Chen GQ, Cui FZ, Kim TN, Kim JO (2000) A mechanistic study of the antibacterial effect of silver ions on Escherichia coli and Staphylococcus aureus. J Biomed Mater Res 52:662–668
Gade AK, Ingle A, Whiteley C, Rai M (2010) Mycogenic metal nanoparticles: progress and applications. Biotechnol Lett 32:593–600
Gajbhiye M, Kesharwani J, Ingle A, Gade A, Rai M (2009) Fungus-mediated synthesis of silver nanoparticles and their activity against pathogenic fungi in combination with fluconazole. Nanomed Nanotech Bio Med 5:382–386
Gole A, Dash C, Ramakrishnan V, Sainker SR, Mandale AB, Rao M, Sastry M (2001) Pepsin–gold colloid conjugates: preparation, characterization and enzymatic activity. Langmuir 5:1674–1679
Henglein A (1993) Physiochemical properties of small metal particles in solution:“microelectrode” reaction, chemisorption, composite metal particles and the atom-to-metal transition. J Physic Chem 7:5457–5471
Ingle A, Gade A, Pierrat S, Sonnichsen C, Rai M (2008) Mycosynthesis of silver nanoparticles using the fungus Fusarium acuminatum and its activity against some human pathogenic bacteria. Curr Nanoscie 4:141–144
Kashyap PL, Kumar S, Srivastava AK, Sharma AK (2013) Myconanotechnology in agriculture: a perspective. World J Microbiol Biotechnol 29:191–207
Kearns GJ, Foster EW, Hutchison JE (2006) Substrates for direct imaging of chemically functionalized SiO2 surfaces by transmission electron microscopy. Anal Chem 78:298–303
Kim JS, Kuk E, Yu KN, Kim JH, Park SJ, Lee HJ, Kim SH, Park YK, Park YH, Hwang CY (2007) Antimicrobial effects of silver nanoparticles. Nanomedicine 3:95–101
Lee HJ, Yeo SY, Jeong SH (2003) Antibacterial effect of nanosized silver colloidal solution on textile fabrics. J Mater Sci 38:2199–2204
Maliszewska I, Szewezk K, Waszak K (2009) Biological synthesis of silver nanoparticles. J Phys 146:1–6
Matrinez-Castanon GA, Nino-Martinez N, Matinez-Gutierrez F, Martinez-Mendoza JR, Ruiz F (2008) Synthesis and antibacterial activity of silver nanoparticles with different sizes. J Nanopart Res 10:1343–1348
Morones JR, Elechiguerra JL, Camacho A, Holt K, Kouri JB, Ramírez JT, Yacaman MJ (2005) The bactericidal effect of silver nanoparticles. Nanotechnology 16:2346–2353
Pal S, Tak YK, Song JM (2007) Does the antibacterial activity of silver nanoparticles depend on the shape of nanoparticles? A study of the Gram negative bacterium Escherichia coli. Appl Environ Microbiol 73:1712–1720
Perez C, Paul M, Bazerque P (1990) Antibiotic assay by agar well diffusion method. Acta Biol Med Exp 15:113–115
Qi L, Xu Z, Jiang X, Hu C, Zou X (2004) Preparation and antibacterial activity of chitosan nanoparticles. Carbohyd Res 16:2693–2700
Raheman F, Deshmukh S, Ingle A, Gad A, Raj M (2011) Silver nanoparticles: novel antimicrobial agent synthesized from an endophytic fungus Pestalotia sp. Isolated from leaves of Syzygium cumini L. Nano Biomed Eng 3:174–178
Rai M, Yadav A, Bridge P, Gade A, Rai MK, Bridge PD (2009) In: Rai M, Bridge PD (eds) Applied mycology myconanotechnology: a new and emerging science. CAB International, New York, pp 258–267
Riddin TL, Gericke M, Whiteley CG (2006) Analysis of the interand extracellular formation of platinum nanoparticles by Fusarium oxysporum f. sp. lycopersici using response surface methodology. Nanotechnology 17:3482–3489
Sadawiski Z, Maliszewska IH, Grochwalska B, Polowezyk I, Kozlechi T (2008) Synthesis of silver nanoparticles using microorganisms. J Mater Sci 26:410–424
Sadhasivum S, Shanmugam P, Yun K (2010) Biosynthesis of silver nanoparticles by Streptomyces hygroscopicus and antimicrobial activity against medically important pathogenic microorganisms. Colloid Surf 81:358–362
Saha S, Chattopadhyay D, Acharya K (2011) Preparation of silver nanoparticles by bio-reduction using Nigrospora oryzae culture filtrate and its antimicrobial activity. J Nanomat Biostruct 6:1519–1528
Sastry M, Ahmad A, Khan MI, Kumar R (2003) Biosynthesis of metal nanoparticles using fungi and actinomycetes. Curr Sci 85:162–170
Shahverdi AR, Fakhimi A, Shahverdi HR, Minaian S (2007) Synthesis and effect of silver nanoparticles on the antibacterial activity of different antibiotics against Staphylococcus aureus and Escherichia coli. Nanomedicine 3:168–171
Sharma VK, Yingard RA, Lin Y (2009) Silver nanoparticles: green synthesis and their antimicrobial activities. Adv Colloid Interf Sci 145:83–96
Thomas V, Yallapu MM, Sreedhar B, Bajpai SK (2007) A versatile strategy to fabricate hydrogel-silver nanocomposites and investigation of their antimicrobial activity. J Colloid Interf Sci 315:389–395
Vigneshwaran N, Ashtaputre NM, Varadarajan PV, Nachane RP, Paralikar KM, Balasubramanya RH (2007) Biological synthesis of silver nanoparticles using the fungus Aspergillus flavus. Mater Lett 261:1413–1418
Warcup JH (1950) Soil plate method for isolation of fungi from soil. Nature 166:117–118
Watanabe T (2002) Pictorial atlas of soil and seeds fungal morphologies of cultured fungi and key to species. CRC Press, USA
Yokoyama K, Welchons K (2007) The conjugation of amyloid beta protein on the gold colloidal nanoparticles surfaces. Nanotechnology 18:105–110
Acknowledgments
The authors would like to thank the authorities of Biology Department, College of Education for Pure Sciences, Basra University (Iraq) for supporting this research work as a part of M Sc. research program scholarship awarded to the second author.
Author information
Authors and Affiliations
Corresponding author
Rights and permissions
About this article
Cite this article
Muhsin, T.M., Hachim, A.K. Mycosynthesis and characterization of silver nanoparticles and their activity against some human pathogenic bacteria. World J Microbiol Biotechnol 30, 2081–2090 (2014). https://doi.org/10.1007/s11274-014-1634-z
Received:
Accepted:
Published:
Issue Date:
DOI: https://doi.org/10.1007/s11274-014-1634-z




